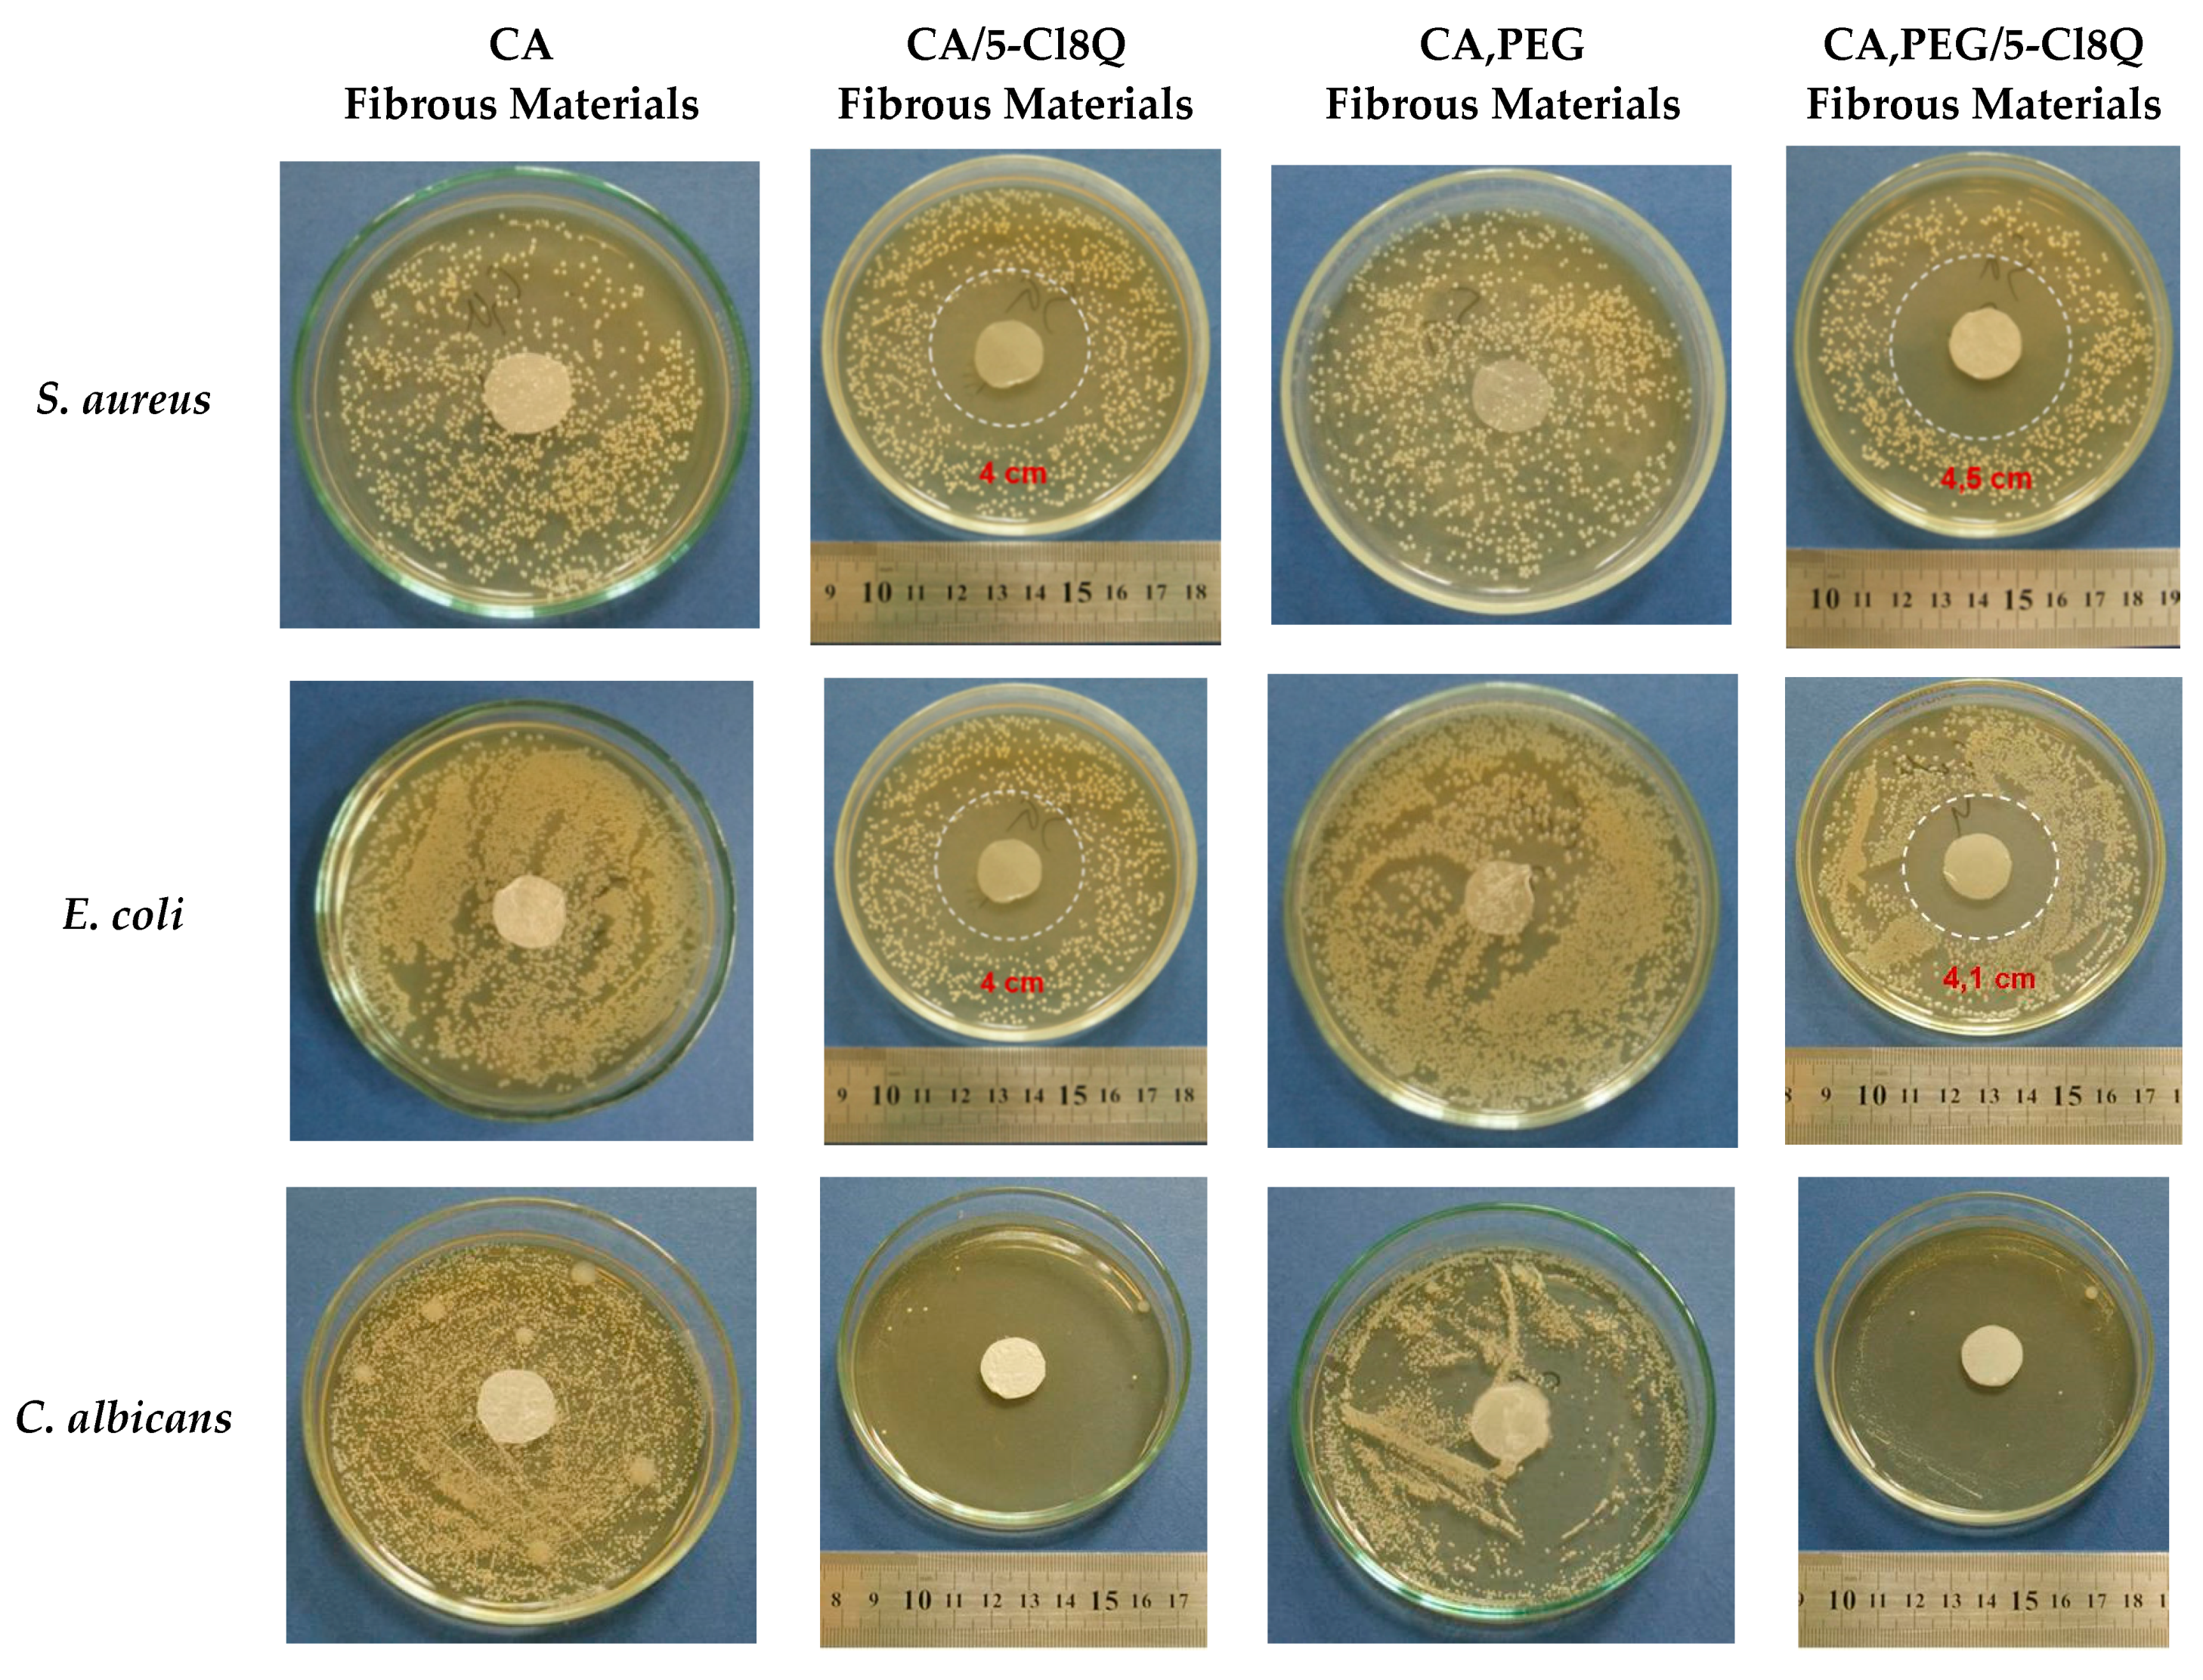

Cellulose Acetate-Based Electrospun Materials with a Variety of Biological Potentials: Antibacterial, Antifungal and Anticancer
Abstract
1. Introduction
2. Materials and Methods
2.1. Materials
2.2. Preparation of Electrospun Fibrous Mats
2.3. Characterization
2.4. Antibacterial Assessment
2.5. MTT Cytotoxicity Assay
2.6. Studying of Apoptotic Induction Using Dual Staining with AO and EtBr
2.7. DAPI Staining
2.8. Statistical Analysis
3. Results and Discussion
3.1. Composition of Fibrous Materials: Morphology and Properties
3.2. Antibacterial and Antimycotic Activities of the Fibrous Materials
3.3. In Vitro Cytotoxicity Tests of the Fibrous Mats against HeLa Cells, SH-4 Cells, and BALB/c 3T3 Fibroblasts
3.4. Analysis of Cell Death by Staining Methods
4. Future Perspectives
5. Conclusions
Supplementary Materials
Author Contributions
Funding
Institutional Review Board Statement
Informed Consent Statement
Acknowledgments
Conflicts of Interest
References
- Thakur, V.; Thakur, M. Processing and characterization of natural cellulose fibers/thermoset polymer composites. Carbohydr. Polym. 2014, 109, 102–117. [Google Scholar] [CrossRef] [PubMed]
- Kargarzadeh, H.; Huang, J.; Lin, N.; Ahmad, I.; Mariano, M.; Dufresne, A.; Thomas, S.; Gałeski, A. Recent developments in nanocellulose-based biodegradable polymers, thermoplastic polymers, and porous nanocomposites. Prog. Polym. Sci. 2018, 8787, 197–227. [Google Scholar] [CrossRef]
- Zeng, Q.; Ou, L.; Zhao, G.; Cai, P.; Liao, Z.; Dong, W.; Liang, X. Preparation and characterization of PEG4000 Palmitate/PEG8000 Palmitate-solid dispersion containing the poorly water-soluble drug andrographolide. Adv. Polym. Technol. 2020, 2020, 4239207. [Google Scholar] [CrossRef]
- Toncheva, A.; Mincheva, R.; Kancheva, M.; Manolova, N.; Rashkova, I.; Dubois, P.; Markova, N. Antibacterial PLA/PEG electrospun fibers: Comparative study between grafting and blending PEG. Eur. Polym. J. 2016, 75, 223–233. [Google Scholar] [CrossRef]
- Song, Y.; Xu, H.; Chen, W.; Zhan, P.; Liu, X. 8-Hydroxyquinoline: A privileged structure with a broad-ranging pharmacological potential. Med. Chem. Commun. 2015, 6, 61–74. [Google Scholar] [CrossRef]
- Tanzer, J.; Slee, A.; Kamay, B.; Scheer, E. Activity of three 8-Hydroxyquinoline derivatives against in vitro dental plaque. Antimicrob. Agents Chemother. 1978, 13, 1044–1045. [Google Scholar] [CrossRef] [PubMed]
- Srisung, S.; Suksrichavalit, T.; Prachayasittikul, S.; Ruchirawat, S.; Prachayasittikul, V. Antimicrobial activity of 8-hydroxyquinoline and transition metal complexes. Int. J. Pharm. 2013, 9, 170–175. [Google Scholar] [CrossRef]
- Surekha, S.; Lincy, J.; Mathew, G. Design, synthesis and screening of newer-8-hydroxyquinoline derivatives as novel anti tubercular agents. Int. J. Appl. Sci. Biotechnol. 2014, 2, 342–358. [Google Scholar] [CrossRef]
- Suwanjang, W.; Prachayasittikul, S.; Prachayasittikul, V. Effect of 8-hydroxyquinoline and derivatives on human neuroblastoma SH-SY5Y cells under high glucose. PeerJ 2016, 4, e2389. [Google Scholar] [CrossRef]
- Topuz, F.; Abdulhamid, M.; Holtzl, T.; Szekely, G. Nanofiber engineering of microporous polyimides through electrospinning: Influence of electrospinning parameters and salt addition. Mater. Des. 2021, 198, 1–11. [Google Scholar] [CrossRef]
- Liu, H.; Gough, C.; Deng, Q.; Gu, Z.; Wang, F.; Hu, X. Recent advances in electrospun sustainable composites for biomedical, environmental, energy, and packaging applications. Int. J. Mol. Sci. 2020, 21, 4019. [Google Scholar] [CrossRef]
- Boateng, J.; Matthews, K.; Stevens, H.; Eccleston, G. Wound healing dressings and drug delivery systems: A Review. J. Pharm. Sci. 2008, 97, 2892–2923. [Google Scholar] [CrossRef]
- Kaassis, A.; Young, N.; Sano, N.; Merchant, H.; Yu, D.; Chatterton, N.; Williams, G. Pulsatile drug release from electrospun poly(ethylene oxide)–sodium alginate blend nanofibres. J. Mater. Chem. B 2014, 2, 1400–1407. [Google Scholar] [CrossRef]
- Topuz, F.; Kilic, M.; Durgun, E.; Szekely, G. Fast-dissolving antibacterial nanofibers of cyclodextrin/antibiotic inclusion complexes for oral drug delivery. J. Colloid Interface Sci. 2021, 585, 184–194. [Google Scholar] [CrossRef] [PubMed]
- Karagoz, S.; Kiremitler, N.; Sarp, G.; Pekdemir, S.; Salem, S.; Goksu, A.; Onses, M.; Sozdutmaz, I.; Sahmetlioglu, E.; Ozkara, E.; et al. Antibacterial, antiviral, and self-cleaning mats with sensing capabilities based on electrospun nanofibers decorated with ZnO nanorods and Ag nanoparticles for protective clothing applications. ACS Appl. Mater. Interfaces 2021, 13, 5678–5690. [Google Scholar] [CrossRef] [PubMed]
- Kumar, S.; Jang, J.; Oh, H.; Jung, B.; Lee, Y.; Park, H.; Yang, K.; Seong, Y.; Lee, J. Antibacterial polymeric nanofibers from zwitterionic terpolymers by electrospinning for air filtration. ACS Appl. Nano Mater. 2021, 4, 2375–2385. [Google Scholar] [CrossRef]
- Stoyanova, N.; Paneva, D.; Mincheva, R.; Toncheva, A.; Manolova, N.; Dubois, P.; Rashkov, I. Poly(L-lactide) and poly(butylene succinate) immiscible blends: From electrospinning to biologically active materials. Mater. Sci. Eng. C 2014, 4, 119–126. [Google Scholar] [CrossRef] [PubMed]
- Spasova, M.; Manolova, N.; Rashkov, I.; Naydenov, M. Electrospun 5-chloro-8-hydroxyquinoline-loaded cellulose acetate/polyethylene glycol antifungal mats against Esca. Polymers 2019, 11, 1617. [Google Scholar] [CrossRef]
- Spasova, M.; Manolova, N.; Markova, N.; Rashkov, I. Superhydrophobic PVDF and PVDF-HFP nanofibrous mats with antibacterial and anti-biofouling properties. Appl. Surf. Sci. 2016, 363, 363–371. [Google Scholar] [CrossRef]
- Spasova, M.; Mincheva, R.; Paneva, D.; Manolova, N.; Rashkov, I. Perspectives on: Criteria for complex evaluation of the morphology and alignment of electrospun polymer nanofibers. J. Bioact. Compat. Polym. 2006, 21, 465–479. [Google Scholar] [CrossRef]
- Rasband, W.S. (1997–2018) ImageJ, U.S. National Institutes of Health, Bethesda, Maryland, USA. Available online: https://imagej.nih.gov/ij/ (accessed on 3 January 2016).
- Mosmann, T. Rapid colorimetric assay for cellular growth and survival: Application to proliferation and cytotoxicity assays. J. Immunol. Methods. 1983, 65, 55–63. [Google Scholar] [CrossRef]
- Wahab, S.; Abdul, A.; Alzubairi, A.; Elhassan, M.; Mohan, S. In vitro ultramorphological assessment of apoptosis induced by zerumbone on (HeLa). J. Biomed. Biotechnol. 2009, 2009, 769568. [Google Scholar] [PubMed]
- Nangare, S.; Jadhav, N.; Ghagare, P.; Muthane, T. Pharmaceutical applications of electrospinning. Ann. Pharm. Fr. 2020, 78, 1–11. [Google Scholar] [CrossRef] [PubMed]
- Wan, S.; Sun, Y.; Qi, X.; Tan, F. Improved bioavailability of poorly water-soluble drug curcumin in cellulose acetate solid dispersion. AAPS PharmSciTech 2012, 13, 159–166. [Google Scholar] [CrossRef]
- Patel, H.; Oza, K. Synthesis, characterization and antimicrobial activity of metal chelates of 5-[1(H)-benzotriazole methylene]-8-quinolinol. E-J. Chem. 2009, 6, 371–376. [Google Scholar] [CrossRef][Green Version]
- Chen, C.; Wang, L.; Huang, Y. Electrospun phase change fibers based on polyethylene glycol/cellulose acetate blends. Appl. Energy 2011, 88, 3133–3139. [Google Scholar] [CrossRef]
- Saratale, R.; Saratale, G.; Ghodake, G.; Choc, S.; Kadama, A.; Kumar, G.; Jeon, B.; Pant, D.; Bhatnagar, A.; Shin, H. Wheat straw extracted lignin in silver nanoparticles synthesis: Expanding its prophecy towards antineoplastic potency and hydrogen peroxide sensing ability. Int. J. Biol. Macromol. 2019, 128, 391–400. [Google Scholar] [CrossRef]
- Hongmanee, P.; Rukseree, K.; Buabut, B.; Somsri, B.; Palittapongarnpim, P. In vitro activities of cloxyquin (5-Chloroquinolin-8-ol) against Mycobacterium tuberculosis. Antimicrob. Agents Chemother. 2007, 51, 1105–1106. [Google Scholar] [CrossRef]
- Pippi, B.; Lopes, W.; Reginatto, P.; Silva, F.; Joaquim, A.; Alves, R.; Silveira, G.; Vainstein, M.; Andrade, S.; Fuentefria, A. New insights into the mechanism of antifungal action of 8-hydroxyquinolines. Saudi Pharm. J. 2019, 27, 41–48. [Google Scholar] [CrossRef]
- Elmore, S. Apoptosis: A review of programmed cell death. Toxicol. Pathol. 2007, 35, 495–516. [Google Scholar] [CrossRef]
- Parnaud, G.; Corpet, D.; Gamet-Payrastre, L. Cytostatic effect of polyethylene glycol on human colonic adenocarcinoma cells. Int. J. Cancer 2001, 92, 63–69. [Google Scholar] [CrossRef]
- Liu, G.; Li, Y.; Yang, L.; Wei, Y.; Wang, X.; Wang, Z.; Tao, L. Cytotoxicity study of polyethylene glycol derivatives. RSC Adv. 2017, 7, 18252–18259. [Google Scholar] [CrossRef]
- Zhang, H.; Meng, T.; Liu, Y.; Chen, Z.; Liu, Y.; Liang, H. Synthesis, characterization and biological evaluation of a cobalt (II) complex with 5-chloro-8-hydroxyquinoline as anticancer agent. Appl. Organometal. Chem. 2016, 30, 730–739. [Google Scholar] [CrossRef]
- Chan-on, W.; Huyen, N.; Songtawee, N.; Suwanjang, W.; Prachayasittikul, S.; Prachayasittikul, V. Quinoline-based clioquinol and nitroxoline exhibit anticancer activity inducing FoxM1 inhibition in cholangiocarcinoma cells. Drug Des. Dev. Ther. 2015, 9, 2033–2047. [Google Scholar]
- Shen, A.; Wu, S.; Chiu, C. Synthesis and cytotoxicity evaluation of some 8-hydroxyquinoline derivatives. J. Pharm. Pharmacol. 1999, 51, 543–548. [Google Scholar] [CrossRef]

Publisher’s Note: MDPI stays neutral with regard to jurisdictional claims in published maps and institutional affiliations. |
© 2021 by the authors. Licensee MDPI, Basel, Switzerland. This article is an open access article distributed under the terms and conditions of the Creative Commons Attribution (CC BY) license (https://creativecommons.org/licenses/by/4.0/).
Share and Cite
Spasova, M.; Manolova, N.; Rashkov, I.; Tsekova, P.; Georgieva, A.; Toshkova, R.; Markova, N. Cellulose Acetate-Based Electrospun Materials with a Variety of Biological Potentials: Antibacterial, Antifungal and Anticancer. Polymers 2021, 13, 1631. https://doi.org/10.3390/polym13101631
Spasova M, Manolova N, Rashkov I, Tsekova P, Georgieva A, Toshkova R, Markova N. Cellulose Acetate-Based Electrospun Materials with a Variety of Biological Potentials: Antibacterial, Antifungal and Anticancer. Polymers. 2021; 13(10):1631. https://doi.org/10.3390/polym13101631
Chicago/Turabian StyleSpasova, Mariya, Nevena Manolova, Iliya Rashkov, Petya Tsekova, Ani Georgieva, Reneta Toshkova, and Nadya Markova. 2021. "Cellulose Acetate-Based Electrospun Materials with a Variety of Biological Potentials: Antibacterial, Antifungal and Anticancer" Polymers 13, no. 10: 1631. https://doi.org/10.3390/polym13101631
APA StyleSpasova, M., Manolova, N., Rashkov, I., Tsekova, P., Georgieva, A., Toshkova, R., & Markova, N. (2021). Cellulose Acetate-Based Electrospun Materials with a Variety of Biological Potentials: Antibacterial, Antifungal and Anticancer. Polymers, 13(10), 1631. https://doi.org/10.3390/polym13101631

